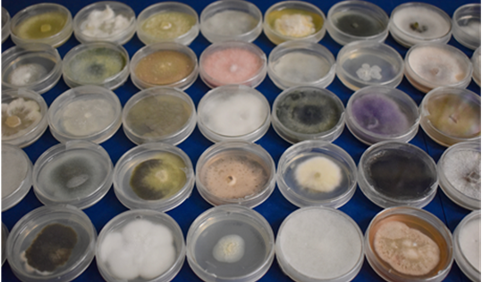

The purpose of the Science Focus Area (SFA) structure at the national laboratories is to encourage, facilitate, and effectively manage integrative and collaborative programs to achieve scientific research and solutions of the highest quality in support of Office of Biological and Environmental Research (BER) goals.
The intent is to take advantage of the national laboratories’ strengths to conduct coordinated, team-oriented research in a manner that is distinct from, but complementary to, research conducted via other institutions.
SFA research programs at the DOE national laboratories must be coherent, cohesive and sustainable programs that reflect coordination and collaboration among individual researchers and teams of investigators, at scientific and management levels across national laboratory divisions and among other institutions, when applicable.
The national laboratories are expected to develop and evolve their research programs over time to identify, build, and anticipate new areas of science and future research needs and challenges. Additionally, as BER’s strategic goals change and as science progresses, the national laboratories are expected to reconfigure SFA programs to meet these changing research needs. They can focus on research within a BER subprogram, across subprograms within a division or across divisions.
At a minimum, each SFA will be reviewed once every three years by external reviewers. For more information, read the BER SFA guiding documents.